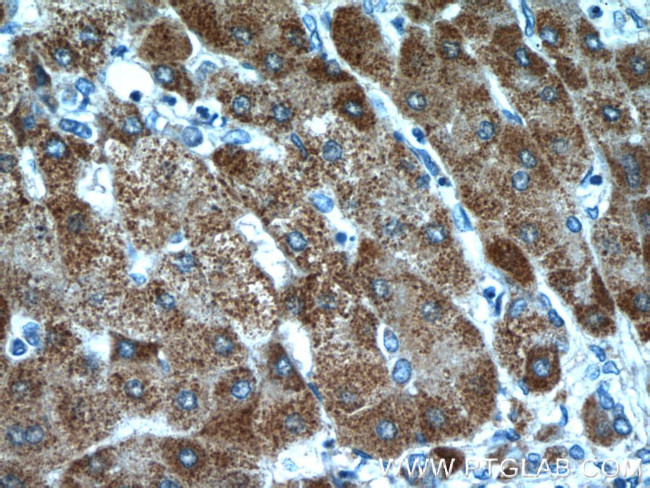
ITIH4 Antibody in Immunohistochemistry (Paraffin) (IHC (P))
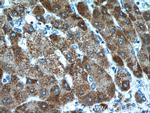
ITIH4 Antibody in Immunohistochemistry (Paraffin) (IHC (P))
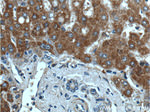
ITIH4 Antibody in Immunohistochemistry (Paraffin) (IHC (P))

Search
Proteintech
ITIH4 Polyclonal Antibody
{{$productOrderCtrl.translations['antibody.pdp.commerceCard.promotion.promotions']}}
{{$productOrderCtrl.translations['antibody.pdp.commerceCard.promotion.viewpromo']}}
{{$productOrderCtrl.translations['antibody.pdp.commerceCard.promotion.promocode']}}: {{promo.promoCode}} {{promo.promoTitle}} {{promo.promoDescription}}. {{$productOrderCtrl.translations['antibody.pdp.commerceCard.promotion.learnmore']}}
产品信息
24069-1-AP
种属反应
宿主/亚型
分类
类型
抗原
偶联物
形式
浓度
规格
纯化类型
保存液
内含物
保存条件
运输条件
产品详细信息
Immunogen sequence: STFFKYYLQ GAKIPKPEAS FSPRRGWNRQ AGAAGSRMNF RPGVLSSRQL GLPGPPDVPD HAAYHPFRRL AILPASATPA TSNPDPAVSR VMNMKIEETT MTTQTPAPIQ APSAILPLPG QSVERLCVDP RHRQGPVNLL SDPEQGVEVT GQYEREKAGF SWIEVTFKNP LVWVHASPEH VVVTRNRRSS AYKWKETLFS VMPGLKMTMD KTGLLLLSDP DKVTIGLLFW DGRGEGLRLL LRDTDRFSSH VGGTLGQFYQ EVLWGSPAAS DDGRRTLRVQ GNDHSATRER RLDYQEGPPG VEISCWSVEL (622-932 aa encoded by BC136393)
靶标信息
The inter-alpha-trypsin inhibitor (ITI, I-alpha-I) family is a classic example of protein-glycosaminoglycoprotein (PGP) complexes. They occur constitutively in plasma at relatively high concentrations and results from alternating combinations of three kinds of heavy chains with a common light chain called the bikunin proteoglycan. Bikunin has two proteinase inhibotor domains and belongs to the Kunitz-type protease inhibitor family; it displays an inhibitory activity against trypsin, leukocyte elastase and plasmin. The heavy chains do not have any protease inhibitory properties but have the capacity to interact in vitro and in vivo with hyaluronic acid and this binding promotes the stability of the extra-cellular matrix. The ITI protein family is suspected of playing a key role in the extra-cellular matrix biology.
仅用于科研。不用于诊断过程。未经明确授权不得转售。
生物信息学
蛋白别名: DKFZp686G21125; Gp120; IHRP; Inter alpha-trypsin inhibitor, heavy chain 4; inter-alpha (globulin) inhibitor H4 (plasma Kallikrein-sensitive glycoprotein); inter-alpha-inhibitor heavy chain 4; Inter-alpha-trypsin inhibitor family heavy chain-related protein; inter-alpha-trypsin inhibitor heavy chain family member 4; Inter-alpha-trypsin inhibitor heavy chain H4; inter-alpha-trypsin inhibitor, heavy chain-like, 1; ITI heavy chain H4; PK-120; Plasma kallikrein sensitive glycoprotein 120; plasma kallikrein-sensitive glycoprotein 120; unnamed protein product
基因别名: GP120; H4P; IHRP; ITI-HC4; Itih-4; ITIH4; ITIHL1; PK-120; PK120; PRO1851
UniProt ID: (Human) Q14624, (Mouse) A6X935
Entrez Gene ID: (Human) 3700, (Mouse) 16427